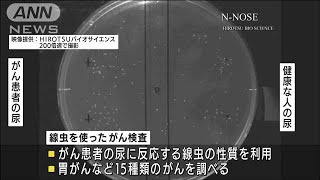
尿1滴で・・・線虫がん検査の拠点が新宿にオープン(2021年7月21日

T*️様 【お値下げ】N-NOSE 線虫ガン検査 HIROTSU BIO SCI 世界初!がんのリスク早期発見サービス「N-NOSE®」 田中麗奈さん出演の
(3210件)
Pontaパス特典
サンキュー配送
6525円(税込)
66ポイント(1%)
Pontaパス会員ならさらに+1%ポイント還元!
送料
(
)
3202
配送情報
お届け予定日:2026.04.10 3:51までにお届け
※一部地域・離島につきましては、表示のお届け予定日期間内にお届けできない場合があります。
ロットナンバー
87957286530
お買い物の前にチェック!

Pontaパス会員なら
ポイント+1%
ポイント+1%
商品説明


ご覧いただきありがとうございます。未開封です。2025年の3月に届きました。2枚目の写真をご覧ください私宛の宛名の部分を剥がしたのですが、あまりきれいに剥がせておらずごめんなさい。検体提出は1ヵ月以内を推奨していますと書いてありますが、1ヵ月以上経ってももちろん問題なく検査ができる事は販売元に確認済みです。
| カテゴリー: | ダイエット・健康>>>健康管理・計測計>>>その他 |
|---|---|
| 商品の状態: | 新品、未使用","新品で購入し、一度も使用していない |
| 配送料の負担: | 送料込み(出品者負担) |
| 配送の方法: | 佐川急便/日本郵便 |
| 発送元の地域: | 東京都 |
| 発送までの日数: | 1~2日で発送 |
レビュー
商品の評価:




 4.4点(3210件)
4.4点(3210件)
- たけ〜よ
- 送料無料、ポイント10倍のため購入しました。当方リピーターですが家族内での消費なら中落ちでも充分です!どうせ切るんですし。 個人的には中落ちで充分だと思ってるため、割高な感がいなめません
- 莉りー
- 臭みもなくサッパリして美味しかったです。 付属の醤油も美味しかったです。
- 稔政
- 数年前からのリピーターです。値段が年々高くなってが残念です(若丸さんだけではないありませんが) 馬刺し中落ちは家族で食べるなら充分です!醤油もサービスはありがたいですし無くなればまたリピします。
- ドンちゃん0828
- 配送まで全く問題ありませんでしたが、クール宅急便の為、時間指定をしなかったので、何回か業者さんに持ち帰りさせてしまいました。 解凍も簡単そうなので、正月に食べるのが、楽しみです!
- nohanohano
- 馬肉はヘルシーな高たんぱく質低カロリーですよね。 またリピートしようと思います。
- cigarbmw
- 子供たちもおいしいといっています。また購入したいです。
- いいんだて
- ちょっと甘みが強いかなー? ニンニク入れたら美味しい
- 黒鳥5147
- 子供達も喜んで食べてます。 また!買いたいです。
- オニキス305
- タレは会津の辛味噌の方が好みです!ぶっちゃけ肉がよいので会津の辛味噌取り扱いしてくれたらリピートしやすいです( ´Д`)y━・~~
- yama_chan1973
- 注文から商品到着までスムーズに対応して頂きありがとうございました。 届いた商品もとてもおいしく次回また頼みたいと思います。
すべて見る
お店の情報
7,367
連絡・応対
4.3
配送スピード
4.3
梱包
4.3